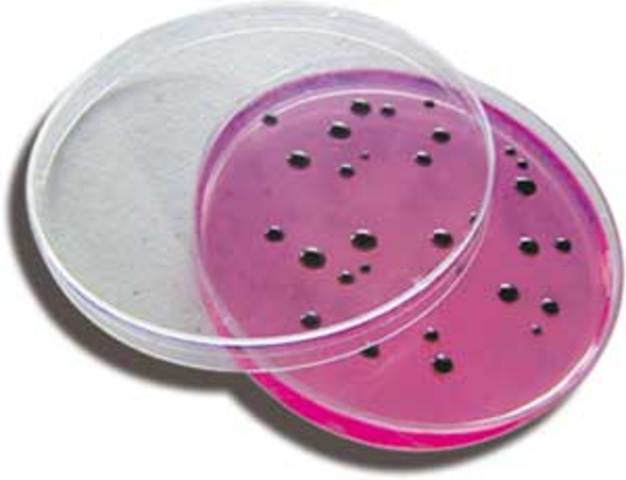
CajasPetri

-
Hans Janssen desarrolla el primer microscopio compuesto.
-
Anton van Leeuwenhoek es el primero en observar bacterias o "animálculos".
-
Edward Jenner desarrolla la primera vacuna contra la viruela humana.
-
Miles Joseph Berkeley descubre un hongo (Phytophthora infestans) que produce la podredumbre de la patata.
-
John Snow realiza el primer estudio epidemiológico del cólera en Londres.
-
Louis Pasteur refuta de manera convincente la teoría de la generación espontánea.
-
Friederich Miescher descubre el DNA (ácido nucleico) en el esperma de trucha.
-
Robert Koch demuestra que el carbunco o ántrax es causado por Bacillus anthracis
-
Carlos Finlay observa que la fiebre amarilla es transmitida por mosquitos.
-
Robert Koch descubre el Mycobacterium tuberculosis.
-
Desarrollo de la tinción de Gram.
-
Louis Pasteur puso a punto una vacuna contra la rabia.
-
Escherich descubre Escherichia coli.
-
Richard Petri introduce el uso de las cajas Petri en Microbiología.
-
Serguéi Winogradski estudia las bacterias del azufre y las bacterias nitrificantes.
-
Dimitri Ivanovski demuestra que el mosaico del tabaco es producido por un virus
-
Fritz Schaudinn y Erich Hoffmann demuestran que el Treponema pálidum es el agente productor de la sífilis.
-
Howard Taylor Ricketts demuestra que la fiebre de las Montañas Rocosas es transmitida por garrapatas, y aisló el microorganismo causante de la enfermedad (que él llamó rickettsia). Falleció por esa enfermedad.
-
Walter Reed confirma que la fiebre amarilla es transmitida por mosquitos
-
Francis Peyton Rous descubre el virus (retrovirus) que produce tumores (sarcomas) en pollos.
-
Frederick Twort descubre los virus que infectan bacterias (bacteriófagos).
-
Frederick Griffith lleva a cabo el descubrimiento de la transformación bacteriana.
-
Helmut Ruska inventa el microscopio electrónico.
-
Frits Zernike desarrolla el microscopio de contraste de fases que permite ver microorganismos vivos.
-
Domagk descubre las sulfamidas, el primer agente quimioterapeútico.
-
Oswald Avery, Colin MacLeod y Maclyn McCarty demuestran que el DNA es el material genético.
-
Alfred Hershey y Martha Chase demuestran que el DNA era el material genético de algunos virus.
-
Norton Zinder y Joshua Lederberg descubren el fenómeno de la transducción generalizada.
-
Woese y George E. Fox reconocen las archeas como el tercer dominio de los seres vivos.
-
Se produce insulina humana usando bacterias Escherichia coli mediante técnicas de ingeniería genética.
-
La Organización Mundial de la Salud declara la erradicación de la viruela.
-
Se comercializó insulina humana
-
Robert Gallo y Luc Montagnier llevan a cabo el aislamiento e identificación del virus del sida.
-
Clements y Bullivant descubren Epulopiscium fishelsoni, la mayor célula procariota.
-
se descubre la bacteria gigante Thiomargarita namibiensis.
-
2009 - se descubre el proceso de esporulación en Mycobacterium
-
Caracterización "in vivo" e "in vitro" del virus H1N1
Looking for a timeline maker?
Create timelines for projects, roadmaps, history, lessons, legal cases, and stories with Timetoast. Timetoast is a timeline maker for work, school, research, and stories.